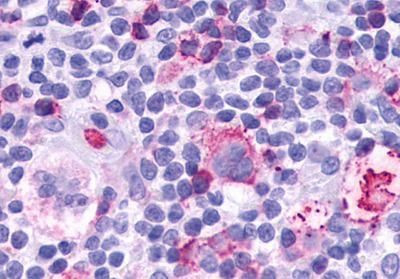
LTB4R Antibody in Immunohistochemistry (Paraffin) (IHC (P))
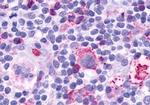
LTB4R Antibody in Immunohistochemistry (Paraffin) (IHC (P))

Search
Invitrogen
LTB4R Polyclonal Antibody
{{$productOrderCtrl.translations['antibody.pdp.commerceCard.promotion.promotions']}}
{{$productOrderCtrl.translations['antibody.pdp.commerceCard.promotion.viewpromo']}}
{{$productOrderCtrl.translations['antibody.pdp.commerceCard.promotion.promocode']}}: {{promo.promoCode}} {{promo.promoTitle}} {{promo.promoDescription}}. {{$productOrderCtrl.translations['antibody.pdp.commerceCard.promotion.learnmore']}}
产品信息
PA1-20738
宿主/亚型
分类
类型
抗原
偶联物
形式
浓度
规格
保存条件
运输条件
RRID
产品详细信息
PA1-20738 detects Leukotriene B4 Receptor in Human and Rat samples.
靶标信息
LTB4R (Leukotriene B4 Receptor) is a member of the GPCR family. It is a receptor for leukotriene B4, a potent chemoattractant involved in inflammation and immune response. It has been reported in blood, bone marrow, brain, heart, liver, and skeletal muscle. In addition, it has been shown to be highly expressed in leukocytes and lymphoid tissues such as spleen, thymus, and lymph node. ESTs have been isolated from B-cell/lung/testis, breast, colon, eye, kidney, skin, spleen, testis, and tonsil libraries.
仅用于科研。不用于诊断过程。未经明确授权不得转售。